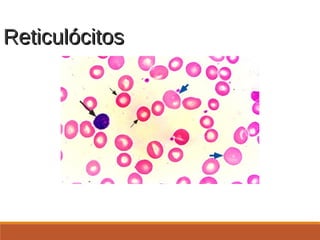
ReticulócitosReticulócitos
http://www.uptodate.com.offcampus.lib.washington.edu/online/content/images/
HEME/9131/Polychromatophilia.jpg
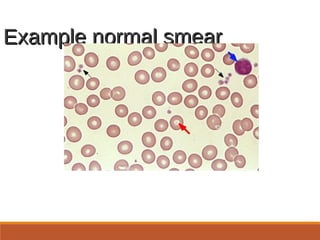
Example normal smearExample normal smear
From UpToDate,
http://www.uptodate.com/online/content/image.do;jsessionid=B
8AAB868DBB1B8B6463E3749C695F04E.1004?
imageKey=HEME%2F9057
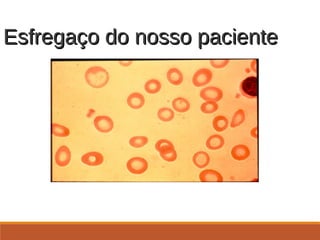
Esfregaço do nosso pacienteEsfregaço do nosso paciente
. 26 anos, sexo feminino, apresentando a avaliação
após a tentativa de doar sangue e estar foi dito que ela
estava anêmica
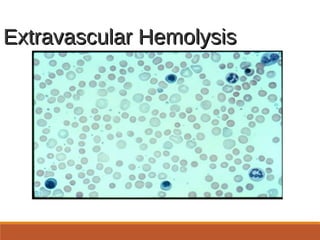
Extravascular HemolysisExtravascular Hemolysis
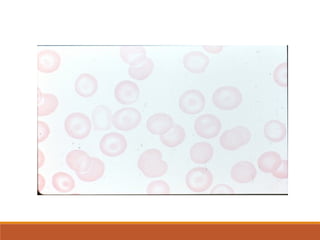

O documento apresenta dois casos clínicos de pacientes com anemia. O primeiro caso é de uma mulher de 26 anos com anemia ferropriva, confirmada por exames laboratoriais. O segundo caso é de uma mulher de 52 anos com lúpus e anemia, sendo discutido o diagnóstico diferencial. O documento também resume as principais causas, avaliação e tratamento da anemia.